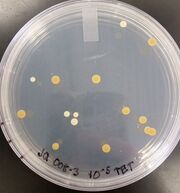
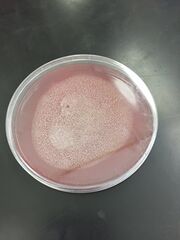
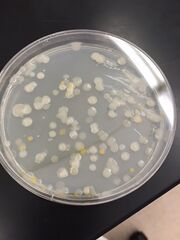

Uploads by Rachel Mary Jones
From OpenWetWare
Jump to navigationJump to search
This special page shows all uploaded files.
| Date | Name | Thumbnail | Size | Description |
|---|---|---|---|---|
| 13:52, 5 February 2016 | IMG 0677.JPG (file) |  |
38 KB | |
| 13:52, 5 February 2016 | IMG 0676.JPG (file) | |
36 KB | |
| 13:52, 5 February 2016 | IMG 0678.JPG (file) |  |
363 KB | |
| 13:52, 5 February 2016 | IMG 0600.JPG (file) | |
26 KB | |
| 13:52, 5 February 2016 | IMG 0599.JPG (file) |  |
27 KB | |
| 13:51, 5 February 2016 | IMG 0674.JPG (file) |  |
344 KB | Wet mount photo |
| 13:51, 5 February 2016 | IMG 0602.JPG (file) |  |
27 KB | |
| 13:51, 5 February 2016 | IMG 0601.JPG (file) | |
29 KB | |
| 13:51, 5 February 2016 | IMG 0590.JPG (file) |  |
25 KB | |
| 13:51, 5 February 2016 | IMG 0589.JPG (file) |  |
29 KB | |
| 17:09, 21 January 2016 | Transect3drawing.jpg (file) |  |
38 KB | This is a drawing of my transect |